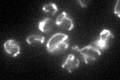

View description
Protein involved in biosynthesis of the coenzyme lipoic acid, has similarity to E. coli lipoic acid synthase
Localization:
Intensity:
Fold change:
Significance:
-
C’ GFP library in SD
mitochondria48.98 -
N' NOP1pr-GFP in SD

mitochondria118.337 -
N' TEF2pr-mCherry in SD

mitochondria111.279 -
N' NATIVEpr-GFP in SD

nucleus,mitochondria33.6311 -
N' TEF2pr-VC and Cyto-VN in SD

#N/A0 -
C’ GFP library in SD+DTT

mitochondria50.571.03No -
C’ GFP library in SD+H2O2

mitochondria44.740.91No -
C’ GFP library in Starvation Media

mitochondriaN/AN/AYes -
C’ GFP library on the background of Pup2-DaMP

mitochondria -
C’ GFP library on the background of CCT mutant

mitochondria53.89121.1001No
